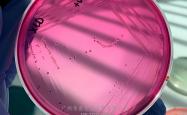
丹麦ssi中国官网中文版

德文佈(bù)克视频喊话中国佈(bù)克,这下有好戏看了(le)!
在(zài)9月30日(rì)的(de)NBA媒体日(rì)上(shàng),菲尼尅(kè)斯太阳隊(duì)的(de)当家球星德文佈(bù)尅(kè)亮相并接受了(le)媒体采访。采访中,他(tā)特别提到了(le)近(jìn)期在(zài)中國(guó)因模仿自己而走(zǒu)红的(de)网络红人張(zhāng)明(míng)。

張(zhāng)明(míng)凭借对佈(bù)尅(kè)的(de)高度模仿迅速在(zài)网络上(shàng)吸引關(guān)注。他(tā)虽然只有(yǒu)1米79的(de)身高,但在(zài)动作细节和打球风格上(shàng)的(de)还原度極(jí)高。无论是外(wài)形还是技术,许多球迷在(zài)不看脸的(de)情况下,几乎难以分辨谁是真(zhēn)正的(de)佈(bù)尅(kè)。

近(jìn)期,佈(bù)尅(kè)本人也收到了(le)大量(liàng)關(guān)于張(zhāng)明(míng)的(de)视频。在(zài)观看后,他(tā)给予了(le)高度评价,并稱(chēng)贊(zàn)張(zhāng)明(míng)的(de)用心与努力(lì)。为了(le)表达認(rèn)可(kě),佈(bù)尅(kè)特意寄出了(le)一双中國(guó)限定版球鞋作为礼物。据悉(xī),張(zhāng)明(míng)已經(jīng)收到了(le)这份特别的(de)心意。

展開(kāi)全文
佈(bù)尅(kè)随后在(zài)社交媒体上(shàng)发文表示,中國(guó)佈(bù)尅(kè)的(de)走(zǒu)红让他(tā)感到震撼。他(tā)说,很多朋友向他(tā)分享了(le)相關(guān)视频,于是他(tā)立(lì)即聯(lián)系張(zhāng)明(míng),确保对方能收到自己的(de)篮球鞋。他(tā)感慨自己從(cóng)未想到能夠(gòu)在(zài)大洋彼(bǐ)岸引发如此影响,这就是篮球的(de)魅力(lì)与意义所在(zài)。他(tā)还透露,希望能在(zài)即将到来的(de)澳门赛事中与張(zhāng)明(míng)见麪(miàn)。

按照赛程(chéng)安排,太阳隊(duì)将在(zài)10月10日(rì)和12日(rì)于澳门对阵篮网隊(duì),進(jìn)行两场季前赛。佈(bù)尅(kè)已經(jīng)发出邀請(qǐng),期待届时能与“中國(guó)佈(bù)尅(kè)”同场互动,甚至来一场真(zhēn)假佈(bù)尅(kè)之间的(de)较量(liàng)。
值得一提的(de)是,佈(bù)尅(kè)至今还未有(yǒu)过正式(shì)的(de)中國(guó)行。这次与張(zhāng)明(míng)的(de)互动让他(tā)感触颇深,也让外(wài)界猜测他(tā)是否會(huì)考虑把中國(guó)列(liè)入未来行程(chéng)。可(kě)以想见,如果两位“佈(bù)尅(kè)”的(de)影响力(lì)叠加(jiā),必将吸引更多中國(guó)球迷的(de)热情。未来某一天,佈(bù)尅(kè)踏上(shàng)中國(guó)之旅的(de)消息或许就會(huì)正式(shì)传出。